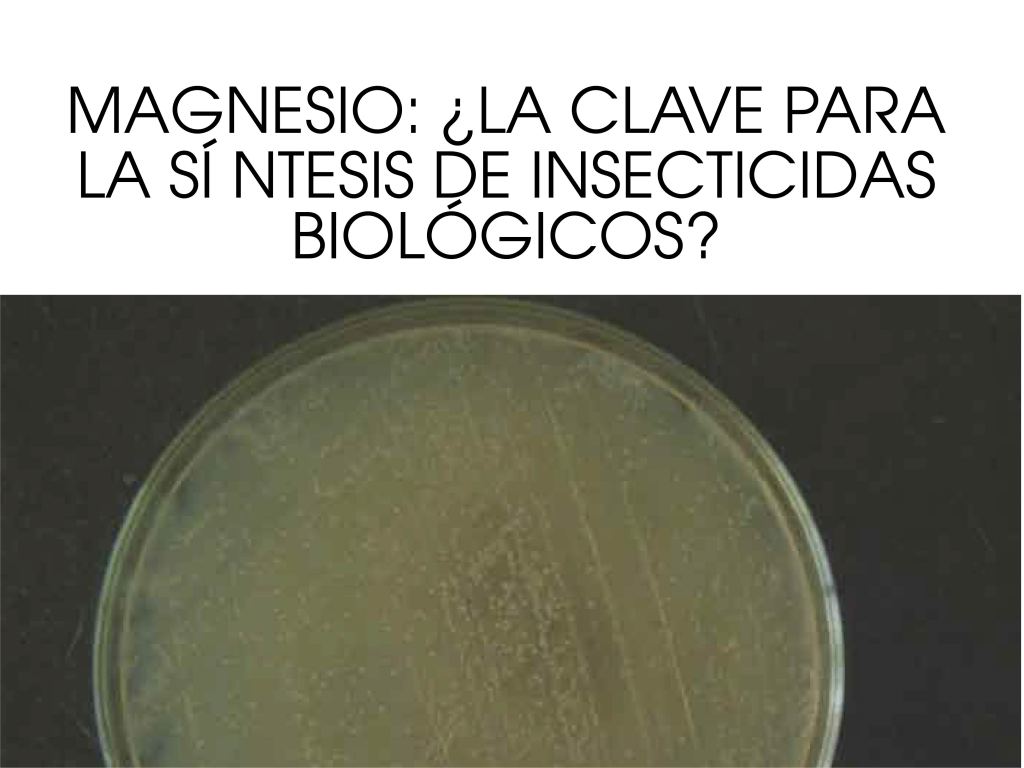

Revista El Astrolabio
Edición 6-1
Enero – Junio 2007

Editorial
Al desarrollar diferentes procesos investigativos y promover la construcción de conocimientos de con un alto nivel de profundización a través de sus Centros de Estudios, el Gimnasio Campestre ha tendido un puente sólido y permanente para que profesores y estudiantes adquieran herramientas y habilidades para acceder al saber, controlar su propio aprendizaje, aplicarlo y enfocarlo hacia nuevos contenidos.
Con esta nueva entrega de nuestra revista de investigación y ciencia, El Astrolabio, damos cuenta de los avances importantes que hemos logrado en la consolidación de una comunidad científica en educación y de la conformación de grupos estructurados de investigación como es el caso de los estudiantes que presentan sus resultados en los artículos sobre Bacillus thuringiensis en el Centro de Biología Molecular, y sobre el impacto medio ambiental del envase tetrabrick en el Centro de Ecología.
Este número cuenta, además, con una autora invitada, presenta resultados de investigaciones en literatura e historia de varios docentes del colegio, así como de los directores de los Centros de Estudios de Astronomía y Sociales y contiene dos propuestas críticas de música y arte relacionadas con el Jazz y con la obra del maestro Nadín Ospina.
Disfrútenla.
Juan Antonio Casas Pardo – Rector

Identificación de señales de radio solares en la frecuencia de 20.1 mhz a partir de las observaciones del año 2005
El Observatorio Julio Garavito dei Gimnasio Campestre viene desarrollando un proyecto de Radioastronomía con el fin de hacer seguimiento al ciclo del Sol captando las señales de radio en la frecuencia de 20.1 MHz generadas en su atmósfera. Para tal efecto se tienen un receptor y una antena dipolo los cuales captan, registran y clasifican las tormentas de radio y otros fenómenos producidos principalmente durante los destellos solares. En 2005 se registraron señales de 130 días las cuales fueron clasificadas y cuyo análisis permitió identificar tormentas de radio relacionadas con destellos y explosiones de radio Tipo III…
Palabras clave: Destellos, explosiones de radio Tipo III, tormentas de ruido, frecuencia de 20.1 MHz.
Efecto de la concentración de magnesio en la producción de endotoxinas en BaciIIus thuringiensis var kurstaki-HD1.
La producción de proteínas cristalinas insecticidas (ICP’s) en Bacillus thuringiensis (Bt) es afectada de manera sustancial por la presencia de elementos metálicos tales como cobre, zinc, calcio, manganeso y magnesio en el medio de cultivo. En el presente estudio se evaluó el efecto del magnesio (Mg+2) en la biosíntesis de ICP’s en BaciIIus thuringierisis var. kurstaki-HD1. Las concentraciones de sulfato de magnesio (MgSO4 ) seleccionadas para la evaluación no afectaron significativamente la producción de cristales tóxicos, hecho que sugiere que cantidades considerablemente menores de magnesio pueden ser suficientes para lograr un efecto de estimulación en la biosíntesis de estas d-endotoxinas….
Palabras clave: Proteína cristalina insecticida, biosíntesis, elemento metálico.

La paleografía como herramienta que posibilita la comprensión de la historia colonial
Las ayudas pedagógicas son un recurso con el que los profesores introducen algunas temáticas de sus asignaturas. Este artículo pretende contribuir con la práctica docente, al señalar la paleografía como herramienta metodológica de la historia, por medio de la cual, se puede facilitar en los estudiantes la comprensión del pasado…
Palabras clave: Historia Colonial, documentos antiguos, paleografía y fuentes primarias.

El caso de la Goleta Peggy
En este artículo, trabajado por estudiantes del Gimnasio Campestre con habilidades en lectura e interpretación de documentos antiguos a partir del cono[1]cimiento de la paleografía, se reconstruye un caso que puede ampliarle al rector el espectro del conocimiento y comprensión de algunas características cotidianas de la convivencia en la mar y la piratería, en tiempos coloniales en el Nuevo Reino de Granada….

Pequeños planteamientos propios de lectura: un paso en la construcción de lectores activos
Se presenta un método y unas estrategias de lectura que, aplicados durante un año lectivo, llevaron a los estudiantes de cuarto grado a hacer planteamientos propios de lectura…
Palabras clave: método, estrategias, lectura, planteamientos propios..

Consumo de tetrabrick y plástico en la población de prejardín en el Gimnasio Campestre
El tetrabrick y el plástico son materiales ampliamente utilizados hoy para el empaque y envasado de una gran variedad de productos alimenticios, gracias a sus características aislantes y de conservación. Sin embargo, estas mismas características deseables para el empaque de alimentos, los hace altamente contaminantes y los convierte en materiales de gran impacto negativo sobre el ambiente ya que se calcula que su periodo de biodegradación es de 450 a 500 años…
Palabras Claves: Tetrabrick, plástico, consumo, ambiente, impacto.

Aurelio Arturo: la palabra del hombre que es el hombre
La poesía del poeta colombiano Aurelio Arturo (1906- 1974), aparecida a finales de los años veinte, fue recibida como única en el panorama lírico colombiano. La gran mayoría de sus críticos -poetas como Arturo- la refieren como una nueva concepción del lenguaje poético que alcanza una dimensión universal. Considerado como el poeta más importante de Colombia en el siglo XX y nombrado como una de las claves del canon poético colombiano en la década de los cuarenta…

El jazz y el arte de la improvisación
El Jazz como lenguaje musical, ha representado un papel primordial en las culturas afro americana y europea del último siglo. La improvisación como elemento esencial en el jazz, es el tema central de este artículo. Algunos aspectos históricos y anécdotas en[1]marcan y dan a conocer los orígenes del jazz y de la improvisación dentro del género. El surgimiento y florecimiento de algunas figuras del jazz como Lester Young y Art Tatum a comienzos del siglo XX, muestran al mundo la trascendencia, particularidad, esencia e identidad de un pueblo a través de la improvisación, cuya acción se ve reflejada en la creatividad y expresividad: características esenciales de un músico de jazz…
Palabras Claves: Jazz, improvisación, big band, Storyville, síncopa, virtuosismo.

Mestizaje en nuestros días
El mestizaje en América se inicia hace más de 500 años con la conquista del nuevo mundo, hecho que se constituye como elemento esencial de la identidad cultural de ese entonces y de ahora. Hoy en día el mundo es mestizo, el auge de los medios de comunicación hacen el intercambio más fácil. Nadín Ospina, artista plástico colombiano, a través de su obra realiza planteamientos de identidad y mestizaje de nuestra cultura, que resaltan la importancia de conocernos a través de iconos ancestrales propios y de entender los símbolos externos…
Palabras Claves: Mestizaje, identidad, Nadín Ospina.
